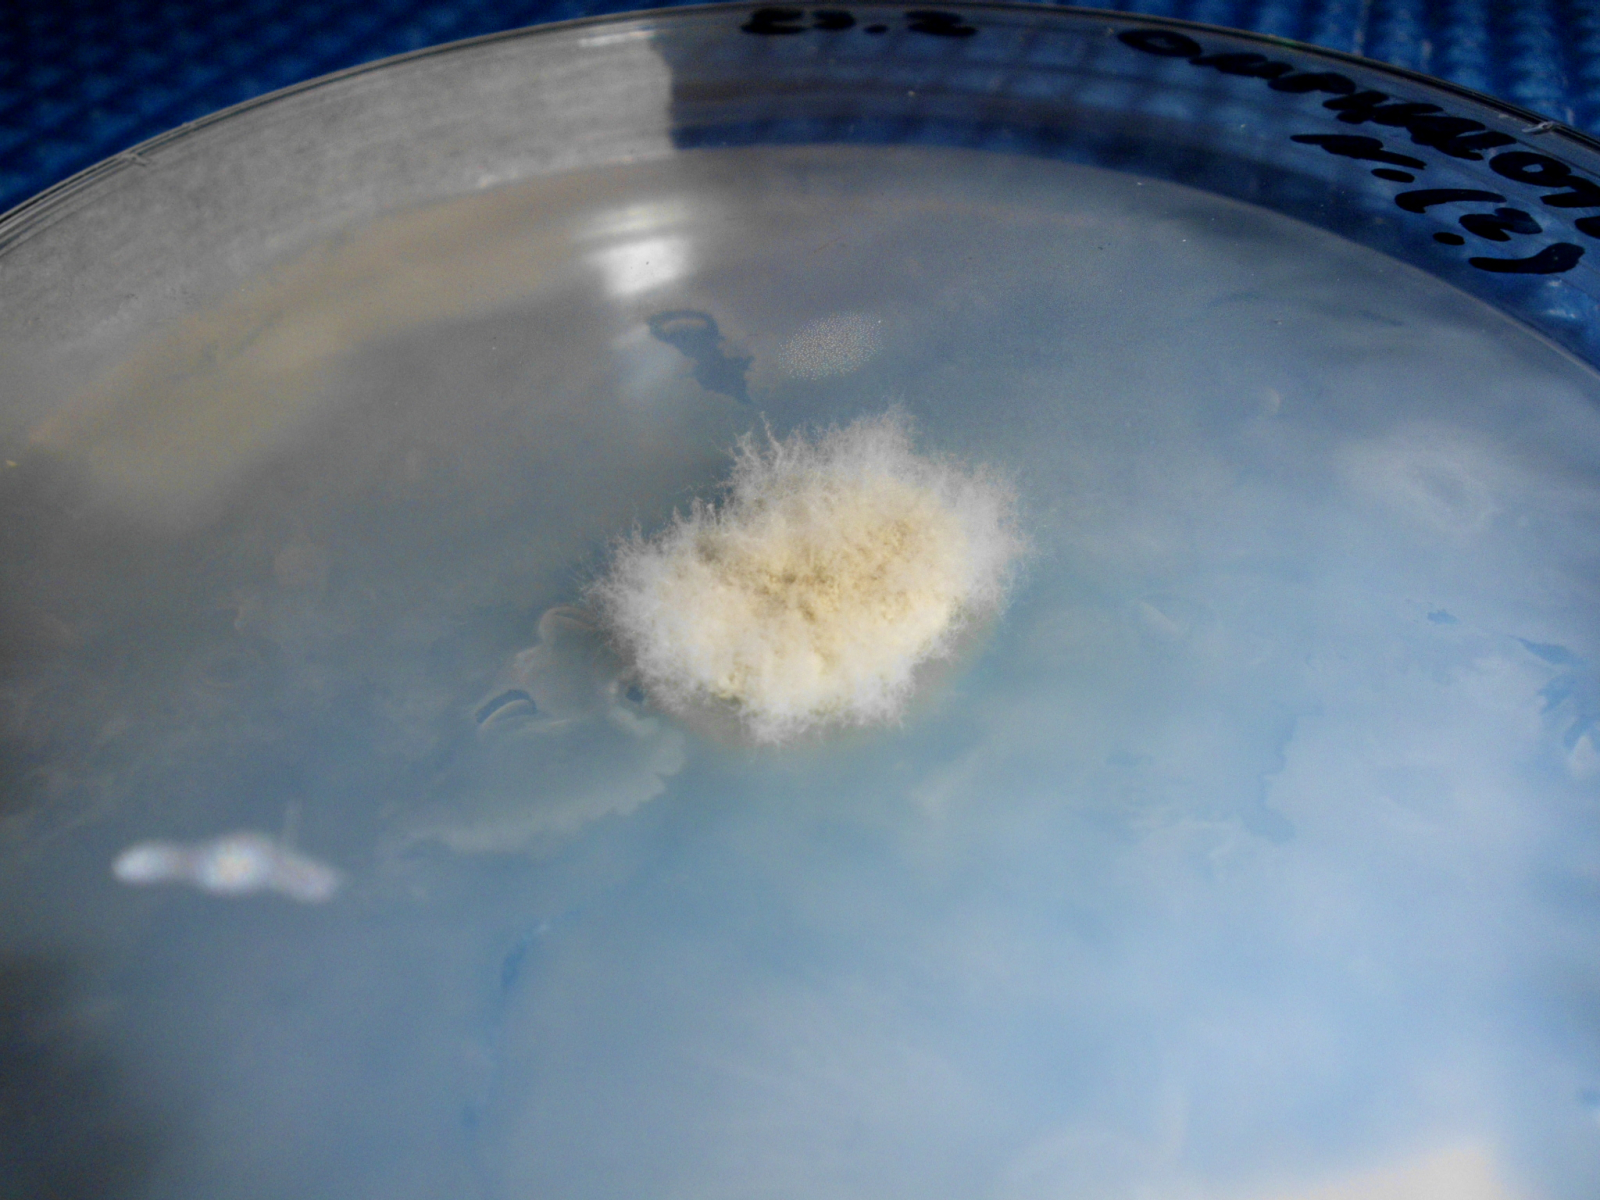

Hallo
Ich habe vor einigen wochen eine handvoll holzduebel erworben, laut haenderlangaben mit "omphalotus nidiformis" bewachsen (ein pilz mit schwach bioluminiszenten
fruchtkoerpern. ob das myzel selbst auch biolum. ist konnte ich nicht in erfahrung bringen.)
Um zu sehen ob ich eine reinkultur erstellen kann habe ich einen der holzduebel in einer petrischale mit kartoffel-dextrose agar
ca. 5 tage bei zimmertemperatur wachsen lassen. den duebel habe ich nur locker auf den agar gelegt. das resultat war zwar verunreinigt mit gruenlichem schimmel,
aber ich habe mehrere stuecke myzel+agar aus dem (scheinbar) sauberen teil der schale auf drei weitere petris mit demselben naehmedium weiterverpflanzt und
das ganze dann noch einmal wiederholt. Ich bin jetzt also bei der 3. generation.
ich bin auch an dem punkt wo ich wissen moechte ob ich da tatseachlich noch omphalotus n. myzel auf der petri habe oder ob es nur noch ein schimmelpilz den ich getrost in jenseits schicken kann!
Fragen:
A) Wie kann ich entscheiden, ggf auch unter verwendung meiner rudimentaeren mikroskopiekenntnisse, dass was ich da habe *kein* schimmelpilz ist? Sieht man es schon am myzel selbst? (nicht durchgehend weiss sonder stellenweise gelblich. siehe fotos im anhang)
B) Kennt jemand eine andere methode um eine reinkultur heranzuzuechten, ausgehend von einem holzduebel?
Vielen dank fuer ein paar ratschlaege von der kompetenten community hier!